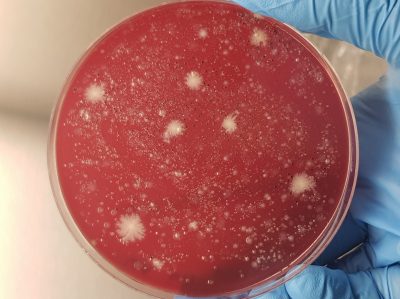
15-Microbiota intestinal estamos llenos de diversidad

Microbiota intestinal, estamos llenos de diversidad
Publicada el 8/12/2025
Título: Microbiota intestinal, estamos llenos de diversidad
Autor: Gracia Luque Aguilera
Centro de Investigación Biomédica (CIBM), Av. del Conocimiento, 19. 18016 Granada
Descripción: Una placa de cultivo de agar sangre columbia de una muestra fecal diluida cultivada en anaerobiosis en el que se observa una gran variedad de colonias con diferentes morfologías, colores y tamaños.